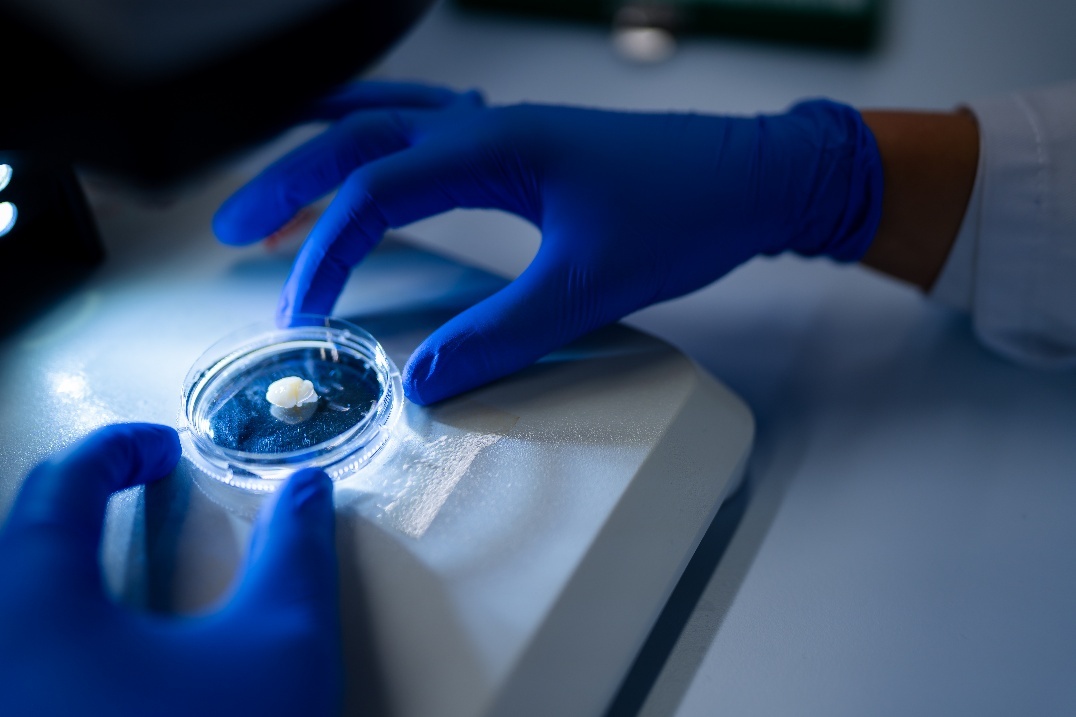

Il settore lituano delle scienze della vita continua a crescere. Attualmente contribuisce per il 2,6% al PIL del Paese, e punta a raggiungere il 5% entro il 2030, un obiettivo che sembra raggiungibile alla luce di una costante crescita annuale del 25%, tra le più rapide nell’Unione Europea. L’impegno della Lituania in questo settore è sottolineato dalla sua posizione al terzo posto tra i paesi OCSE per quanto riguarda gli investimenti in ricerca e sviluppo nella biotecnologia. Questa dedizione si traduce in impressionanti risultati per quanto riguarda le esportazioni, con il 92% dei prodotti farmaceutici e sanitari fabbricati in Lituania commercializzati in oltre 100 Paesi, tra cui Stati Uniti, Regno Unito e Germania.
Nel campo delle neuroscienze, in particolare, sono importanti anche i collegamenti con l’Italia, in particolare la collaborazione tra il Life Sciences Centre dell’Università di Vilnius e l’Epigenetics and Neurobiology Research Unit dell’European Molecular Biology Laboratory di Roma.
La Dott.ssa Urtė Neniškytė è la Group leader del VU-EMBL Partnership Institute for Genome Editing Technologies, dove il suo lavoro sulle neuroscienze molecolari e cellulari si concentra sulla corretta creazione e perfezionamento delle reti neurali nel cervello umano. Durante le prime fasi di sviluppo, il cervello umano ha un gran numero di connessioni neurali; queste sono molto dense nell’infanzia e, man mano che lo sviluppo procede, le connessioni non necessarie vengono eliminate per garantire una trasmissione più rapida ed efficiente di informazioni utili all’interno del cervello. Questo è un processo simile alla potatura dei rami di un albero per garantire che dia più frutti.
In genere, tra l’infanzia e l’età adulta, un cervello sano perde metà delle sue connessioni neurali iniziali e quando ciò non accade, insorgono complicazioni come i disturbi dello spettro autistico. Dal 2011, la ricerca ha stabilito che le cellule immunitarie del cervello sono importanti nella regolazione del cosiddetto processo di potatura delle connessioni neurali e la comunicazione tra neuroni e cellule immunitarie del cervello è l’obiettivo principale della ricerca condotta dalla VU-EMBL Partnership.
Riguardo la sua esperienza presso l’EMBL, Neniškytė ha commentato: “Con Cornelius Gross all’EMBL di Roma, ho esplorato i segnali molecolari che definiscono quali connessioni neuronali devono essere potate durante lo sviluppo. Abbiamo appena pubblicato un articolo correlato a questo lavoro. Alla Vilnius University, continuiamo a studiare le basi molecolari del raffinamento dei circuiti neuronali.
“È importante notare che, da quando siamo diventati parte del VU-EMBL Partnership Institute, stiamo anche introducendo tecniche di editing genetico e sviluppando nuovi vettori per portare strumenti di editing genetico all’interno del cervello dei mammiferi, oltre a studiare la loro applicazione in alcune malattie con componenti neurologiche”.
Le tecnologie di editing genetico come CRISPR-Cas9 possono aiutare a sviluppare modelli di disturbi che determinano una regolazione disfunzionale nei geni, anziché studiare semplicemente gli effetti a valle, e questo, insieme ai vettori di somministrazione in vivo, è una tecnologia promettente nello sviluppo di trattamenti per questi disturbi.
L’unità di ricerca di epigenetica e neurobiologia dell’EMBL, guidata dal Dott. Cornelius Gross, si concentra sull’indagine interdisciplinare delle connessioni tra genoma, ambiente e funzione neurale, creando una connessione tra gli scienziati che studiano il controllo dell’espressione genica e coloro che esaminano l’elaborazione sensoriale e il controllo comportamentale. L’attività scientifica dell’unità di ricerca è supportata in loco da numerose strutture di base, tra cui editing genetico e ingegneria virale, imaging ottico e citometria a flusso.
L’ambizione della Lituania nelle scienze della vita ha dato vita, tra l’altro, a Bio City, un progetto da 7 miliardi di euro di Northway Group per creare il più grande campus di biotecnologia d’Europa. Il completamento è previsto per il 2030, lo sviluppo coprirà un’area equivalente a 10 campi da calcio e impiegherà 2.000 specialisti.
Il progetto Bio City è esaustivo, con centri di terapia genica e virologia, strutture per la ricerca sulle cellule staminali e laboratori di biostampa 3D. Come spiega Jekaterina Kalinienė, responsabile del BioTech Lab presso l’Innovation Agency Lithuania, Bio City posizionerà la capitale lituana Vilnius come un importante hub biotecnologico nella regione baltica.
Inoltre, per sostenere il successo della ricerca lituana in questo campo, anche a livello internazionale, l’Innovation Agency Lithuania organizza Life Sciences Baltics, l’evento internazionale che nel 2023 ha riunito più di 800 persone da 33 Paesi, tra cui Polonia, Estonia, Lettonia, Germania, Corea del Sud, Taiwan, Regno Unito e Italia. L’edizione di quest’anno si terrà a Vilnius dal 17 al 18 settembre 2025, con l’obiettivo di adattare l’esperienza dell’evento a ciascun partecipante, garantendo il ruolo più rilevante e di impatto per tutti. In quanto principale forum di scienze della vita nella regione, funge da hub globale per i massimi esperti di biotecnologia, farmaceutica, dispositivi medici e assistenza sanitaria.
L’evento è concepito per massimizzare le opportunità di networking, promuovendo connessioni e collaborazioni che guidano l’innovazione e la crescita nel settore delle scienze della vita. In particolare, tra gli argomenti della conferenza all’evento, ci saranno “CRISPR and Beyond: The Future of Gene Editing in Personalised Medicine” e “Breakthroughs in Neurotechnology: Shaping the Future of Medicine”.